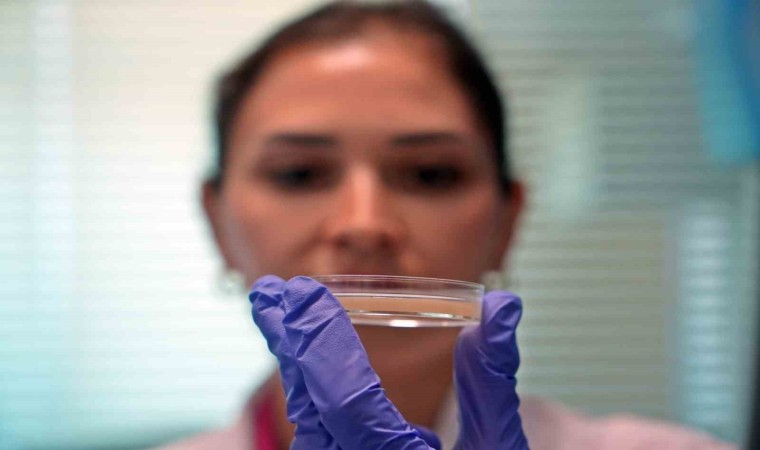

Antalya Büyükşehir Belediyesi Antalya Su ve Atıksu (ASAT) Genel Müdürü İbrahim Kurt, son günlerde kamuoyunda su tarifelerinde yapılan değişiklik sonrası çıkan haberlere açıklık getirerek, "Suya yüzde 446 oranında zam gelmesi söz konusu değildir. 5 ton su yarım damacana su fiyatındadır. Akaryakıt ve elektriğe gelen son zamlarla birlikte ASAT’a 1 metreküp suyun maliyeti 60 TL’dir. Halkın büyük çoğunluğunun kullandığı 20 metreküpe kadar su tarifesinde bir zam olmamıştır. Antalya Büyükşehir Belediyesi olarak Türkiye’nin en ucuz suyunu tüketen 6’ncı Büyükşehir Belediyesiyiz" dedi.
ASAT Genel Müdürü İbrahim Kurt, Antalya Büyükşehir Belediyesi ASAT Genel Kurulunda su tarifelerinde yapılan değişiklik sonrası kamuoyunda su zammı ile ilgili çıkan haberlere ilişkin bir değerlendirmede bulundu. Sosyal medyada su tarifelerindeki değişikliklere ilişkin farklı haberlerin dolaştığına dikkat çeken İbrahim Kurt, "Suya yüzde 500, yüzde 446 zam geldi diye haberler gördük. Böyle bir zam söz konusu değildir. Antalya’daki yaklaşık 1 milyon 565 bin abonemizin, 1 milyon 231 bin mesken abonesidir. 5 metreküpe kadar su kullanan abone yüzde 27’lik bir kısma denk gelir. 5 metreküpe kadar su kullanan aboneleri koruyacak şekilde bir tarife düzenlemesi yapıldı. 5 ton su yarım damacana; 50 TL olacak şekilde bir düzenleme yapılmıştır" dedi.
"0-20 metreküp su kullanımı aynı fiyatta kaldı"
Artan elektrik ve akaryakıt maliyetlerine rağmen su tarifelerinde kademe kademe vatandaşın lehine olacak şekilde düzenleme yapıldığını ifade eden ASAT Genel Müdürü Kurt, şu bilgileri verdi:
"Nüfusun büyük çoğunluğunun kullandığı 1-20 metreküp kademesinde bir artış yapılmamış 20,47 TL olarak sabit kalmıştır. 40 metreküp üzeri kullanımlar da ise su kaynaklarının azaldığını dikkate alarak, halkımızı su tasarrufuna yöneltmek amacıyla suyun tonu 50,34 TL olarak belirlenmiştir. Sonuç olarak 0-5 metreküp kullanan vatandaşları koruyacak bir düzenleme yaptık. Başkanımızın da her zaman belirttiği gibi küçük esnafı koruyan bir düzenleme yapıldı. Antalya’daki 133 bin 802 ticarethane abonesinin yüzde 71’i 0-10 metreküp arası su kullanmaktadır. Bu kademede fiyatında bir değişiklik yapılmayarak küçük esnaf desteklenmiştir."
"Öğrenciye 10 ton su bedava"
Muhittin Başkan’ın öğrenci evlerine yönelik başlattığı 5 ton ücretsiz su kullanımının 10 tona çıkarıldığını açıklayan ASAT Genel Müdürü İbrahim Kurt, konuşmasını şöyle sürdürdü:
"Şehit aileleri ve gazilere yüzde 90, engelli bireylere yönelik yüzde 40 indirim uygulanmaktadır. Hayvancılıkla uğraşan abonelere yönelik 50 ton su indirimli olarak verilmeye devam edecektir. Yine belediyemizden sosyal kart kullanan vatandaşlara yönelik 10 metreküpe kadar su kullanımı ücretsiz olarak devam edecek."
"En ucuz suyu kullanan 6’ncı büyükşehir Antalya"
Son günlerde kamuoyunun yanlış yönlendirilerek ‘Antalya Türkiye’nin en pahalı suyunu kullanıyor’ şeklinde bir algı oluşturulmakta olduğuna dikkati çeken Kurt, “Antalya Büyükşehir Belediyesi olarak, Türkiye’deki 30 Büyükşehir arasında Türkiye’nin en ucuz suyunu kullanana 6’ncı Büyükşehir Belediyesiyiz. Ticari aboneliklerde ise Türkiye’nin en ucuz suyunu kullanan 5’inci Büyükşehir Belediyesiyiz” ifadelerini kullandı.
"1 ton suyun maliyeti 60 TL"
Antalya ve 19 ilçede yerleşik nüfus olarak 2 milyon 700 bin vatandaşa, yerli ve yabancı misafir olarak yılda 25 milyon vatandaşa hizmet verdiklerini dile getiren İbrahim Kurt, sözlerini şöyle tamamladı:
"Antalya merkezdeki suyumuzun yüzde 98’ini yer altından sondajla elektrik kullanarak temin ediyoruz. Antalya’nın coğrafi konumundan kaynaklı bin 600 depomuz, bin 200 sondajımız 7/24 çalışmaktadır. Halkımıza sağlıklı ve kaliteli su ulaştırmak, atık suyu arıtmak, sahillerimizi, denizimizi, çevremizi korumak amacıyla çalışmalarımızı 7/24 hiç durmadan sürdürüyoruz. ASAT’ın tüm bu tesisleri elektrikle çalışan tesislerdir. Türkiye’de elektrik harcaması en fazla olan kurumuz. Elektriğe yapılan zamdan önce aylık ortalama 185 milyon TL elektrik faturası geliyordu. Son zamlarla birlikte aylık elektrik faturamız 250 milyon TL’ye yükselmiştir ve ASAT’a 1 metreküp suyun maliyeti 60 TL olmuştur. ASAT Genel Müdürlüğü olarak Antalyalı vatandaşlarımıza ucuz, sağlıklı ve kaliteli suyla buluşturmanın yanında yeni yatırımlarımıza da devam edeceğiz."

Yorum Yazın
E-posta hesabınız sitede yayımlanmayacaktır. Gerekli alanlar * ile işaretlenmişdir.